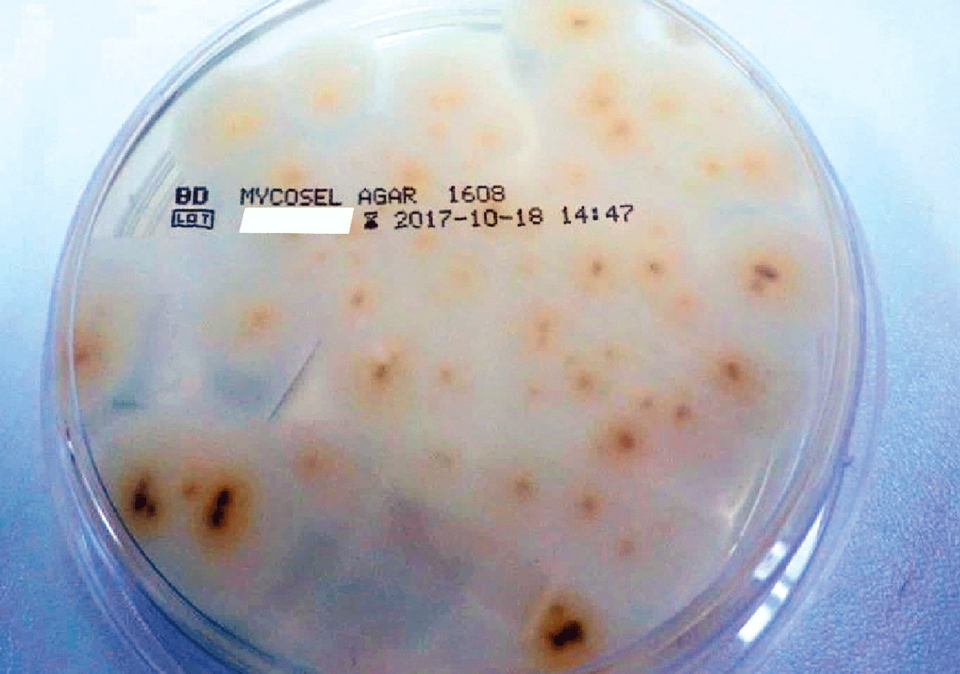
Im Labor bestätigte sich eine Infektion mit Trichophyton erinacei.

Tinea corporis durch Igel-Dermatophyt
 Hautbefund bei stationärer Aufnahme (links). Im Labor bestätigte sich eine Infektion mit Trichophyton erinacei (rechts).
© Wilhelm T, Vandersee S. Wehrmedizinische Monatsschrift 2018; 62: 398-399 © Beta Verlag & Marketinggesellschaft mbH, Bonn
Hautbefund bei stationärer Aufnahme (links). Im Labor bestätigte sich eine Infektion mit Trichophyton erinacei (rechts).
© Wilhelm T, Vandersee S. Wehrmedizinische Monatsschrift 2018; 62: 398-399 © Beta Verlag & Marketinggesellschaft mbH, Bonn
Seit neun Wochen klagte die Patientin über einen vom Oberbauch bis in die Extremitäten reichenden, stark juckenden Hautschlag. Der niedergelassene Dermatologe hatte erfolglos mit verschiedenen topischen Externa behandelt und schließlich zum Ausschluss einer linearen IgA-Dermatose an Spezialisten des Bundeswehrzentralkrankenhauses Koblenz überwiesen. Klinisch imponierten erythematöse, teilweise pustulöse Plaques mit krustösen Begrenzungen sowie gruppiert stehende ekzemartige Hautveränderungen. Als Vorerkrankungen gab die Patientin ein Kraniopharyngeom mit Chiasma-Kompression an. Die Biopsat-Histopathologie ergab Zeichen einer bullösen und pustulösen Dermatitis mit Kokken-Besiedlung.
Schon alleine das klinische Bild machte eine lineare IgA-Dermatose eher unwahrscheinlich. Vielmehr sprach die Befundkonstellation für eine Impetigo bullosa, auch der Verdacht auf eine Tinea corporis stand im Raum. Aufgrund der ausgeprägten ekzematösen Komponente therapierten die Fachärzte zu Beginn lokal mit zweimal täglich Betamethasondipropionat/Clotrimazol – mit sehr mäßigem Erfolg – und stellten nach Bekanntwerden der Histopathologie mit dem Bild einer Impetigo bullosa kurzfristig auf Betamethasonvalerat/Fusidinsäure zweimal täglich um – ebenfalls mit sehr mäßigem Erfolg.
Therapie mit Terbinafin, Ciclopirox und Antihistaminika
Dann meldete sich das mykologische Labor: Es hatte im entnommenen Hautmaterial Pilzbestandteile nachgewiesen. Die Kliniker reagierten mit einer systemischen antimykotischen Behandlung mit 250 mg Terbinafin einmal täglich und topisch Ciclopirox-Creme zweimal täglich, dazu eine antihistaminerge Therapie mit einmal täglich 5 mg Desloratadin. Langsam besserten sich die Symptome.
Die Patientin lebte mit zwei Igeln zusammen
Nach vier Wochen eine erneute Nachricht vom Mykologielabor: In den Kulturen wuchs Trichophyton erinacei, ein vor allem bei Igeln vorkommender Dermatophyt. Tatsächlich hatte die Patientin angegeben, zwei Igel als Haustiere zu halten.
Quelle Text und Abb.: Wilhelm T, Vandersee S. Wehrmedizinische Monatsschrift 2018; 62: 398-399 © Beta Verlag & Marketinggesellschaft mbH, Bonn